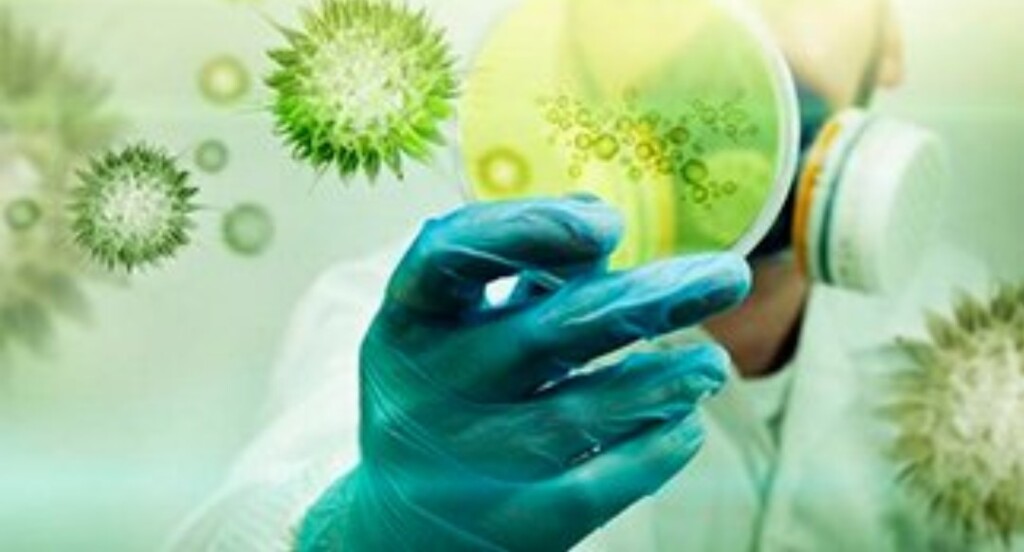

Краснодар проводит дезинфекцию подъездов

Все управляющие компании кубанской столицы обязали вести обязательную ежедневную дезинфекцию домофонов, дверных ручек и перил в подъездах многоквартирных домов. В настоящее время, по данным вице-мэра Краснодара Александра Нарижного, в городе более 230 управляющих компаний, а также около 750 ТСЖ и ЖСК.
«Всем направили информацию с требованием разместить в подъездах памятки о профилактике распространения коронавирусной инфекции. Все эти памятки уже должны быть везде размещены. Кроме того, управляющая компания обязана организовать обязательную регулярную дезинфекцию мест общего пользования в подъездах», - сказал заместитель главы Краснодара.
Если информация о профилактике не размещена или обработку не проводят, жителей просят сообщать об этом в свою управляющую компанию или в городское управление по жилищным вопросам.
Под термином «дезинфекция» подразумевается комплекс мер, направленных на уничтожение патогенной микрофлоры – возбудителей заболеваний (вирусов, бактерий) и продуктов их жизнедеятельности (токсинов).
Главная задача дезинфекционных мероприятий – предотвращение распространения инфекции за счет блокирования всех возможных механизмов передачи.
Открытие микромира послужило мощным толчком для развития санитарии и гигиены.
Медицинские умы находились в постоянном поиске способов профилактики инфекционных заболеваний и уничтожения их возбудителей. В конце XIX века на помощь пришли химики, предложив ряд препаратов, активных в отношении вирусов, бактерий и других простейших микроорганизмов.
С ростом городов и увеличения плотности населения пришло осознание, что дезинфекция должна носить профилактический характер: проще не допустить эпидемии, чем локализовать выявленный очаг и устранить последствия.
В настоящее время служба дезинфекции включает в себя органы здравоохранения, центры гигиены и эпидемиологии, станции дезинфекции и стерилизации, дезинфекционные отделы ведомственных организаций.
Различают три вида дезинфекции в зависимости от целей и способов:
1. Профилактическая.
Как понятно из названия, необходимые действия проводятся для предотвращения возможного возникновения и распространения очага инфекции.

Основными объектами являются лечебные учреждения, детские и учебные заведения, места общего пользования и массового скопления людей (общежития, хостелы, вокзалы, транспорт и т.п.); предприятия по производству, транспортировке и хранению продуктов питания; рынки, склады, бани, парикмахерские, спорткомплексы, сооружения для водозабора, водопроводная сеть и др.
На предприятиях, где в соответствии с санитарно-эпидемиологическими правилами необходима постоянная дезинфекция, мероприятия проводятся собственными силами и средствами (например, постоянная дезинфекция воды из открытых водозаборов). Качество проводимых мероприятий периодически отслеживается контролирующими организациями.
При необходимости разового или периодического проведения дезинфекции работы выполняются сотрудниками специальных компаний.
2. Текущая.
Этот вид дезинфекции необходим по месту пребывания больных инфекционными заболеваниями, а также бактерионосителей.
Такая дезинфекция организуется медицинскими работниками, которые обучают лиц, осуществляющих уход, правильному проведению дезинфекционных мероприятий (изоляция больного, личная гигиена, утилизация отходов, уборка с применением спецсредств, профилактика заражения).
Для обеззараживания используются средства бытовой химии, активные в отношении патогенной микрофлоры. Особенно важна текущая дезинфекция в лечебных учреждениях для предотвращения развития внутрибольничных инфекций.
Регулярные обработки всех помещений проводятся строго по утвержденному графику (при необходимости – чаще). Все поверхности обрабатываются моющими средствами, содержащими дезинфектанты.
3. Заключительная. Включает в себя мероприятия, направленные на полное уничтожение возбудителей заболевания после выздоровления, перевода в другое помещение, а иногда, к сожалению, и смерти больного.

Методы дезинфекции
Колонии патогенных микроорганизмов могут расти на любых поверхностях (стены, пол, мебель), тканях (белье, текстиль), в объеме воздуха или жидкости.
В каждом случае подбирается определенный способ дезинфекции, максимально эффективный в отношении вероятных или реальных возбудителей заболеваний.
Все методы по уничтожению вирусов, бактерий и других микроорганизмов можно разделить на несколько видов:
* Механический. Патогенная микрофлора и продуцируемые токсины уничтожаются специальными предметами для уборки. К механической дезинфекции относятся: мойка, уборка с применением специального инвентаря (щетки, скребки, губки, салфетки), стирка, протирание поверхностей, снятие слоя зараженного грунта и т.п.
* Физический. Микроорганизмы уничтожаются за счет воздействия физических факторов (ультразвук высокой частоты, пропаривание (редко – вымораживание), ультрафиолетовое излучение с определенной длиной волны, СВЧ-обработка, стерилизация рентгеновским излучением, облучение в инфракрасном спектре, стерилизация при высокой температуре).
* Химический. Вирусы, бактерии и опасные токсины уничтожаются (разрушаются) под действием химических препаратов с дезинфицирующим эффектом (хлор, карболовая кислота, перекись водорода и др.).
* Биологический. Уничтожение патогенной микрофлоры осуществляется за счет микробов-антагонистов (термофильных микробов). Этот вид дезинфекции применяется для обеззараживания сточных вод, канализационных коллекторов, компостных и силосных ям – т.е. носит узконаправленный характер.
* Комбинированный. Подразумевается любое сочетание вышеприведенных методов.
В повседневной жизни для профилактики заражения инфекционными заболеваниями достаточно соблюдать простые правила личной гигиены и санитарии.
Бытовая дезинфекция — это перечень несложных, но очень эффективных действий: мыть руки, регулярно проводить влажную уборку и проветривание квартиры, следовать правилам содержания животных, обрабатывать поврежденный кожный покров специальными средствами, в период эпидемий носить ватно-марлевые повязки.
При возникновении каких-либо вопросов или опасений за свое здоровье можно обратиться в ближайшую санэпидемстанцию, сотрудники которой дадут грамотную консультацию, а в случае необходимости порекомендуют профильную компанию, специализирующуюся на проведении дезинфекции.
Будьте здоровы!
Ссылка, Википедия, газета "ь"
В ваших подъездах проводится дезинфекция?
Проголосуйте, чтобы увидеть результаты
Какой должен быть штат у УК, чтобы этот бред, принимаемый чинушами, не знающими работу технички, уборщика, дворника, воплотить в жизнь?! Создавайте летучие отряды и вперёд!
Не надо никаких отрядов создавать, есть специализированные организации со штатом профессионалов своего дела. Надо просто поднять попу с дивана и привлечь их к дезинфекционным мероприятиям!
Александр Олегович "специализированные организации со штатом профессионалов" бесплатно делать ничего не будут
Как вы думаете с кого сдерут деньги за санобработку подьездов?
Правильно - включат в квартплату жильцам
Так что лозунг "Создавайте летучие отряды и вперёд!" как-то ближе. 
Молодцы краснодарцы, покажите пример всей стране!
👍🔥🌿🌺🌿
Вирус наводит чистоту.
Хоть немного задумаемся, что чистота-залог здоровья
Вирус он многому научит
